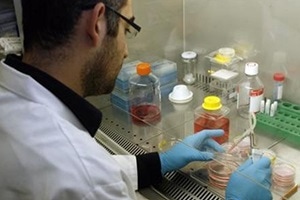
The team was able to differentiate the stem cells into osteoblasts. (Reuters) The team was able to differentiate the stem cells into osteoblasts. (Reuters)

Scientists have developed a new stem cell-containing bio-ink that allows 3D printing of complex living tissues which may be used for surgical implants.
The bio-ink contains two different polymer components: a natural polymer extracted from seaweed, and a sacrificial synthetic polymer used in the medical industry, and both had a role to play.
The synthetic polymer causes the bio-ink to change from liquid to solid when the temperature is raised, and the seaweed polymer provides structural support when the cell nutrients are introduced.
“Designing the new bio-ink was extremely challenging,” said lead researcher Dr Adam Perriman from the University of Bristol in the UK.
“You need a material that is printable, strong enough to maintain its shape when immersed in nutrients, and that is not harmful to the cells. We managed to do this, but there was a lot of trial and error before we cracked the final formulation,” said Perriman.
“The special bio-ink formulation was extruded from a retrofitted benchtop 3D printer, as a liquid that transformed to a gel at 37 degrees Celsius, which allowed construction of complex living 3D architectures,” he said.
The team was able to differentiate the stem cells into osteoblasts – a cell that secretes the substance of bone – and chondrocytes, cells that have secreted the matrix of cartilage and become embedded in it, to engineer 3D printed tissue structures over five weeks, including a full-size tracheal cartilage ring.
“What was really astonishing for us was when the cell nutrients were introduced, the synthetic polymer was completely expelled from the 3D structure, leaving only the stem cells and the natural seaweed polymer,” said Perriman.
“This, in turn, created microscopic pores in the structure, which provided more effective nutrient access for the stem cells,” he said.
The findings could eventually lead to the ability to print complex tissues using the patient’s own stem cells for surgical bone or cartilage implants, which in turn could used in knee and hip surgeries.
The study was published in the journal Advanced Healthcare Materials.